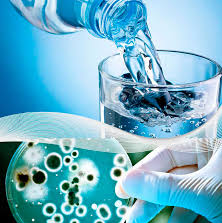

- Profesor: Axel David Esteban Fuentes
- Profesor: Gabriel Paolo Gamboa Ochoa
En este curso estudiaremos lo relacionado con el agua superficial
(hidrología superficial), de una manera integral, relacionando los usos que se
le dan con la calidad y cantidad del recurso agua, para poder conducir los
procesos de manejo, aprovechamiento, planeación y administración del agua,
considerando a los pobladores como parte fundamental de estos
- Profesor: Nelson Sebastian Escobar Reyes
- Profesor: Gabriel Paolo Gamboa Ochoa
El concepto denominado también “pensamiento sistémico”, “visión sistémica” o “enfoque sistémico” y el “paradigma de sistemas” se fundamentan en la llamada “Teoría General de Sistemas” (T.G.S.), por lo que el estudio de esta teoría durante el maestrante proporcionará conceptos, definiciones y expresiones del lenguaje que nos permitirá hablar con mayor precisión de los “fenómenos de sistemas” que podemos identificar y comprender a nuestro alrededor.
Los problemas ambientales, sociales, económicos vinculados a la gestión de recurso hídricos requieren, Ser un “pensador sistémico” implica ser más consciente de nuestro desempeño personal y profesional, así como ser conscientes del entorno que nos rodea para comprenderlo de formas más precisa y tomar decisiones más acertadas que nos permitan acompañar de forma eficiente y efectiva en los sistemas con los que interactuamos. requiere involucrarnos en nuevas ciencias emergentes, la física y química cuántica, el holismo, la complejidad entre otras
- Profesor: Orsival Alebí Fuentes Bámaca
- Profesor: Gabriel Paolo Gamboa Ochoa